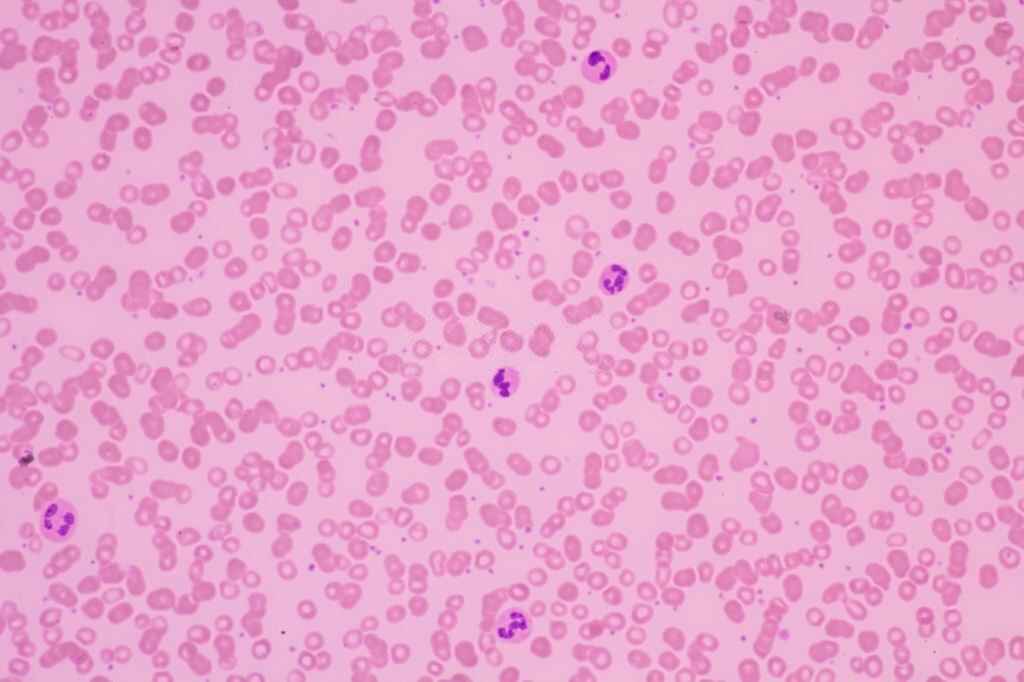
https://myhealth-redcliffelabs.redcliffelabs.com/media/blogcard-images/3547/0b766ef8-c41f-42a5-82f4-0eae64142ab3.jpg

Platelet Count: Low vs. Normal vs. High Range in Human

Medically Reviewed By
Dr Divya Rohra
Written By Prekshi Garg
on Feb 28, 2022
Last Edit Made By Prekshi Garg
on Jan 9, 2025
The platelet count refers to the average amount of platelets present in your blood. Platelets or thrombocytes are the blood components involved in blood clotting during some injury. The normal platelet level in the blood facilitates adequate clotting of the blood during an emergency. The abnormally high or low levels of platelet can be an indication of some underlying health complications. In this article, you will know what level of platelets can be dangerous according to your age and gender.
What Level of Platelets can be Dangerous?
Normally the platelet count in an individual ranges between 1,50,000 - 4,50,000 platelets/ microliter of blood. The platelet count below 50,000 platelets/microliter of blood is considered a low platelet count. A platelet count above 4,50,000 platelets/microliter of blood is considered a high platelet count. However, the range of normal platelet count depends upon your age and gender. According to a study, the low, medium, and high platelet count in individuals of different ages and gender are tabulated below:
| S.No. | Age Group (years) | Males Platelet Count ( X 109/L ) | Females Platelet Count ( X 109/L ) | ||||
| Low Platelet Count | Medium Platelet Count | High Platelet Count | Low Platelet Count | Medium Platelet Count | High Platelet Count | ||
| 1. | < 15 | 396 - 441 | 441 - 484 | 452 - 503 | 396 - 441 | 441 - 484 | 452 - 503 |
| 2. | 15 - 64 | 320 - 359 | 358 - 366 | 361 - 388 | 345 - 363 | 401 - 410 | 422 - 457 |
| 3. | > 64 | 304 - 363 | 344 - 360 | 337 - 420 | 307 - 349 | 375 - 394 | 366 - 441 |
What is the Normal Range of Platelet Count in Males?
The normal range of platelet count is different in males and females. The platelet count in general decreases with increasing age. As per the study, the approximate normal platelet count range in adult males (above the age of 18 years) is tabulated below:
| S.No. | Age Group (in years) | Approximate Normal Platelet Count ( X 109/L ) |
| 1. | 18 - 34 | 240 |
| 2. | 35 - 49 | 245 |
| 3. | 50 - 64 | 235 |
| 4. | 65 - 74 | 220 |
| 5. | > 75 | 215 |
What is the Normal Range of Platelet Count in Females?
The platelet count in females is generally higher than in males after puberty. As per the study, the approximate normal range of platelet count in adult females (above the age of 18 years) is tabulated below:
| S.No. | Age Group (in years) | Approximate Normal Platelet Count ( X 109/L ) |
| 1. | 18 - 34 | 240 |
| 2. | 35 - 49 | 245 |
| 3. | 50 - 64 | 235 |
| 4. | 65 - 74 | 230 |
| 5. | > 75 | 220 |
[embed]https://youtu.be/vM4f-cruTrs[/embed]
What is the Normal Range of Platelet Count in Children?
The platelet count is different in males and females less than 18 years. As per the study, the approximate normal platelet count range in children (less than 18 years of age) is tabulated below:
| S.No. | Age Group (in years) | Approximate Normal Platelet Count ( X 109/L ) in Males | Approximate Normal Platelet Count ( X 109/L ) in Females |
| 1. | < 5 | 340 | 325 |
| 2. | 5 - 9 | 310 | 310 |
| 3. | 10 - 14 | 280 | 290 |
| 4. | 15 - 17 | 250 | 250 |
Takeaway
The platelet count is an important parameter calculated in the complete blood count (CBC) test. The normal platelet level in your body ensures proper clotting of blood in case of any injury or cut. The abnormal levels of platelets can lead to some serious health issues. Now that you know the levels of platelet count specific for your age and gender, you can better analyze your blood report and health condition.
Frequently Asked Questions (FAQs)
-
How can I get my platelet count tested?
The platelet count test is a part of the complete blood count (CBC) test. You can easily book your test at Redcliffe Labs by either calling our center or booking a test online from our official website. We will send our phlebotomist to your place to collect your blood sample free of cost.
-
How much will a platelet count test cost me?
The platelet count test, that is, a complete blood count test, will cost you approximately Rs 249/- at Redcliffe Labs all over India.
-
What can lead to a high platelet count?
The high platelet count is generally due to iron deficiency, cancer, spleen removal, bone marrow disease, certain infections, and medicines.
-
What can lead to a low platelet count?
The low platelet count is generally due to factors like
- Not enough platelets produced in the bone marrow
- Destruction of the platelets in the liver or spleen
- Destruction of the platelets in the bloodstream
- Chemotherapy or radiation given as a part of cancer treatment
- Autoimmune disorder
- Certain drugs or medicines
Leave a comment
3 Comments
Geetha Sivadas
Apr 14, 2025 at 7:24 AM.
My platelet count is 130000 when chkd last week and CBC IS 10.37 IS THIS LOW FOR.ME I am 72 year old
Myhealth Team
Apr 16, 2025 at 2:50 PM.
Aapki platelet count 1,30,000 hai, jo thoda low hai, lekin agar koi symptoms nahi hain toh chinta ki baat nahi. CBC 10.37 thoda low ho sakta hai, par yeh umar ke hisaab se normal ho sakta hai. Doctor se consult karna achha rahega.
Janice Tatoy Abadinas
Nov 18, 2024 at 11:30 AM.
Is 266 platelet count normal in a 5 year old girl?
Myhealth Team
Nov 21, 2024 at 12:03 PM.
A platelet count of 266,000/μL (266) is within the normal range for a 5-year-old girl. The typical platelet count for children is usually between 150,000 and 450,000 per microliter of blood. However, it's always a good idea to consult a pediatrician if you have concerns or if any symptoms are present.
larry
Apr 17, 2024 at 7:48 PM.
my platelets are stable at 78 is good number ?
Myhealth Team
Apr 20, 2024 at 6:52 AM.
A platelet count of 78,000 per microliter is lower than the typical reference range (150,000 to 450,000 platelets per microliter) and may indicate thrombocytopenia, a condition characterized by a low platelet count. Please consult about this with your doctor for further finding.



